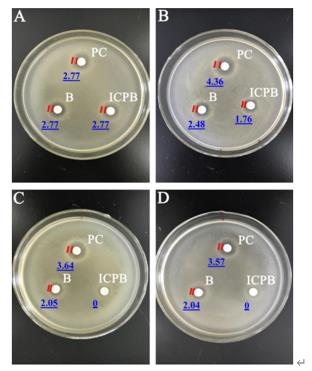

1、中文標題:用于可見光催化的共軛聚合物
引自:C Dai, B Liu.Conjugated polymers for visible-light-driven photocatalysis. Applied Energy Environ. Sci., 2020, 13, 24-52.
 r1K新型光催化網(wǎng)_水庫治理_河道治理_水生態(tài)修復(fù)_水環(huán)境治理與修復(fù)_江蘇雙良環(huán)境科技有限公司
r1K新型光催化網(wǎng)_水庫治理_河道治理_水生態(tài)修復(fù)_水環(huán)境治理與修復(fù)_江蘇雙良環(huán)境科技有限公司圖1 本文綜述了用于光催化的π-共軛聚合物的研究進展。
r1K新型光催化網(wǎng)_水庫治理_河道治理_水生態(tài)修復(fù)_水環(huán)境治理與修復(fù)_江蘇雙良環(huán)境科技有限公司 r1K新型光催化網(wǎng)_水庫治理_河道治理_水生態(tài)修復(fù)_水環(huán)境治理與修復(fù)_江蘇雙良環(huán)境科技有限公司
r1K新型光催化網(wǎng)_水庫治理_河道治理_水生態(tài)修復(fù)_水環(huán)境治理與修復(fù)_江蘇雙良環(huán)境科技有限公司圖2 (a) 聚合物半導(dǎo)體光催化的主要過程(D:電子給體;A:電子受體);(b)影響其光催化性能的關(guān)鍵因素。
r1K新型光催化網(wǎng)_水庫治理_河道治理_水生態(tài)修復(fù)_水環(huán)境治理與修復(fù)_江蘇雙良環(huán)境科技有限公司 r1K新型光催化網(wǎng)_水庫治理_河道治理_水生態(tài)修復(fù)_水環(huán)境治理與修復(fù)_江蘇雙良環(huán)境科技有限公司共軛聚合物作為傳統(tǒng)無機半導(dǎo)體光催化的替代品,近年來得到了積極的研究。這是由于其獨特的優(yōu)勢,低成本,高化學穩(wěn)定性,和分子可調(diào)光電子性質(zhì)。本文綜述了近年來π-共軛聚合物在可見光催化領(lǐng)域的研究進展,包括水分解、二氧化碳還原、有機轉(zhuǎn)化和有機染料降解等。特別強調(diào)聚合物結(jié)構(gòu)的變化如何影響其物理化學性質(zhì)和光催化活性。這種結(jié)構(gòu)-活性關(guān)系分析可以指導(dǎo)共軛聚合物的合理分子設(shè)計,從而提高光催化活性。
r1K新型光催化網(wǎng)_水庫治理_河道治理_水生態(tài)修復(fù)_水環(huán)境治理與修復(fù)_江蘇雙良環(huán)境科技有限公司2、中文標題:石墨氮化碳@鋯酸銀納米復(fù)合材料(gC3N4@Ag2ZrO3):一種具有高效可見光催化活性和光催化滅活細菌的II型異質(zhì)結(jié)催化劑r1K新型光催化網(wǎng)_水庫治理_河道治理_水生態(tài)修復(fù)_水環(huán)境治理與修復(fù)_江蘇雙良環(huán)境科技有限公司引自:Das RS, Warkhade SK , Kumar A , et la. Journal of Alloys and Compounds, 2020(846) 155770,Graphitic carbon nitride @ silver zirconate nanocomposite(gC3N4@Ag2ZrO3): A Type-II heterojunction for an effective visible light photocatalysis and bacterial photo-inactivation.
r1K新型光催化網(wǎng)_水庫治理_河道治理_水生態(tài)修復(fù)_水環(huán)境治理與修復(fù)_江蘇雙良環(huán)境科技有限公司  r1K新型光催化網(wǎng)_水庫治理_河道治理_水生態(tài)修復(fù)_水環(huán)境治理與修復(fù)_江蘇雙良環(huán)境科技有限公司
r1K新型光催化網(wǎng)_水庫治理_河道治理_水生態(tài)修復(fù)_水環(huán)境治理與修復(fù)_江蘇雙良環(huán)境科技有限公司圖1 不同光催化劑劑量對革蘭氏陽性菌—枯草芽孢桿菌(B. Subtilis)(a)和革蘭氏陰性菌—大腸桿菌(E. coli)(b)活性的抑制作用;光照催化時間對細胞活性的影響(c)。
r1K新型光催化網(wǎng)_水庫治理_河道治理_水生態(tài)修復(fù)_水環(huán)境治理與修復(fù)_江蘇雙良環(huán)境科技有限公司光催化能簡單、高效的氧化降解有機污染物,同時抑制細菌生長。因此,我們利用共沉淀法合成了新的光催化劑gC3N4@Ag2ZrO3,該復(fù)合納米光催化劑具有提高可見光光催化效率和光催化滅活細菌的效果。gC3N4@Ag2ZrO3納米復(fù)合材料通過XRD和XPS分析確定,并通過FE-SEM、HR-TEM和BET分析獲得其形貌數(shù)據(jù)。結(jié)果表明,gC3N4薄膜均勻地覆蓋在Ag2ZrO3納米顆粒上,形成II型異質(zhì)結(jié)催化劑。當30 wt%的gC3N4覆蓋在Ag2ZrO3顆粒表面時,II型催化劑gC3N4@Ag2ZrO3的活性達到99.7%。光催化活性的提高歸因于光生載流子的分離和活性自由基的形成。在提高光催化效率的同時,gC3N4@Ag2ZrO3納米復(fù)合材料對大腸桿菌和枯草芽孢桿菌等微生物也表現(xiàn)出良好的光滅活作用。
r1K新型光催化網(wǎng)_水庫治理_河道治理_水生態(tài)修復(fù)_水環(huán)境治理與修復(fù)_江蘇雙良環(huán)境科技有限公司
3、中文標題:活化碳布并同時沉淀二氧化鈦納米線,以增強吸附和光催化性能
引自:Jin-Ming Wu? , Qing-Er Zhao. Activation of carbon cloth and concurrent precipitation of titania nanowires for enhanced adsorption and photocatalysis performance. Applied Surface Science.527(2020)146779.
 r1K新型光催化網(wǎng)_水庫治理_河道治理_水生態(tài)修復(fù)_水環(huán)境治理與修復(fù)_江蘇雙良環(huán)境科技有限公司
r1K新型光催化網(wǎng)_水庫治理_河道治理_水生態(tài)修復(fù)_水環(huán)境治理與修復(fù)_江蘇雙良環(huán)境科技有限公司垂直排列的TiO
2納米線由于具有高比表面積和增加的電荷分離能力從而表現(xiàn)出優(yōu)異的光活性;然而對目標污染物的有限吸附能力阻礙了光催化降解水中污染物。我們在此介紹一種溫和的方法,在碳布上沉淀可調(diào)厚度為1.5–4.5μm的銳鈦礦型TiO2納米線陣列,從而同時獲得高吸附容量和優(yōu)異的光活性。與沉積在金屬Ti基底上的TiO
2納米線陣列相比,其吸附容量可忽略不計,負載在活性炭布上的TiO
2納米線在紫外光照射下對水中的羅丹明B染料分子和無色磺基水楊酸具有更高的光催化降解效率。薄膜厚度的增加對負載在活性炭布上的TiO
2納米線的光活性的提高比金屬鈦箔上的更有效。目前的研究證實了使用高吸附性基底可大大提高一維納米結(jié)構(gòu)TiO
2陣列的光活性的可行性。
r1K新型光催化網(wǎng)_水庫治理_河道治理_水生態(tài)修復(fù)_水環(huán)境治理與修復(fù)_江蘇雙良環(huán)境科技有限公司 r1K新型光催化網(wǎng)_水庫治理_河道治理_水生態(tài)修復(fù)_水環(huán)境治理與修復(fù)_江蘇雙良環(huán)境科技有限公司4、中文標題:光催化-生物降解反應(yīng)器模型中鹽酸四環(huán)素去除和礦化的研究r1K新型光催化網(wǎng)_水庫治理_河道治理_水生態(tài)修復(fù)_水環(huán)境治理與修復(fù)_江蘇雙良環(huán)境科技有限公司引自:Yue M , Houfeng X , Zhiquan Z , et al. Model-based evaluation of tetracycline hydrochloride removal and mineralization in an intimately coupled photocatalysis and biodegradation reactor[J]. Chemical Engineering Journal, 2018, 351:967-975.
r1K新型光催化網(wǎng)_水庫治理_河道治理_水生態(tài)修復(fù)_水環(huán)境治理與修復(fù)_江蘇雙良環(huán)境科技有限公司光催化與生物降解緊密耦合(ICPB)在難降解污染物降解中顯示出巨大的優(yōu)勢,然而,尚未開發(fā)出用于模擬ICPB性能的動力學模型,主要難度是確定光催化與生物降解的關(guān)系。在本研究中,我們開發(fā)了一個簡易的動力學模型,通過假設(shè)所有可生物降解的光催化產(chǎn)物都能立即被生物利用來預(yù)測目標污染物(鹽酸四環(huán)素;TCH)的去除和礦化。結(jié)合二階光催化動力學模型和Monod生物降解模型,我們研究了ICPB中光催化與生物降解之間的相互作用。
r1K新型光催化網(wǎng)_水庫治理_河道治理_水生態(tài)修復(fù)_水環(huán)境治理與修復(fù)_江蘇雙良環(huán)境科技有限公司利用優(yōu)化軟件對實驗數(shù)據(jù)進行非線性回歸擬合得到動力學方程中的參數(shù)。我們的實驗結(jié)果表明,8h內(nèi)TCH和化學需氧量(COD)的去除效果很好,分別高達94%和70%。TCH僅在4h內(nèi)轉(zhuǎn)化為無毒的中間產(chǎn)物。顯然,動力學模型能較好地預(yù)測TCH和COD的去除率,并與實驗數(shù)據(jù)吻合較好R
2>0.92。模型證實了ICPB反應(yīng)器中,生物降解在加速TCH及其中間產(chǎn)物去除和礦化中起主要作用,如ICPB反應(yīng)器比單獨光催化反應(yīng)的動力學系數(shù)k1高10%。所建立的模型準確地預(yù)測了ICPB的效率并揭示了ICPB的作用機制。
r1K新型光催化網(wǎng)_水庫治理_河道治理_水生態(tài)修復(fù)_水環(huán)境治理與修復(fù)_江蘇雙良環(huán)境科技有限公司 r1K新型光催化網(wǎng)_水庫治理_河道治理_水生態(tài)修復(fù)_水環(huán)境治理與修復(fù)_江蘇雙良環(huán)境科技有限公司
r1K新型光催化網(wǎng)_水庫治理_河道治理_水生態(tài)修復(fù)_水環(huán)境治理與修復(fù)_江蘇雙良環(huán)境科技有限公司圖1 ICPB前和ICPB穩(wěn)定階段海綿載體的SEM圖像。(a)和(c)分別為ICPB前和ICPB穩(wěn)定階段的外部圖像,(b)和(d)分別為ICPB前和ICPB穩(wěn)定階段的內(nèi)孔圖像
r1K新型光催化網(wǎng)_水庫治理_河道治理_水生態(tài)修復(fù)_水環(huán)境治理與修復(fù)_江蘇雙良環(huán)境科技有限公司 r1K新型光催化網(wǎng)_水庫治理_河道治理_水生態(tài)修復(fù)_水環(huán)境治理與修復(fù)_江蘇雙良環(huán)境科技有限公司
r1K新型光催化網(wǎng)_水庫治理_河道治理_水生態(tài)修復(fù)_水環(huán)境治理與修復(fù)_江蘇雙良環(huán)境科技有限公司圖2 20mg/LTCH在0h(A)、1h(B)、4h(C)和8h(D),采用PC(可見光光催化)、B(生物降解)和ICPB(光催化-生物降解耦合)對金黃色葡萄球菌的抑制作用。B組為附著生物膜的載體在黑暗環(huán)境下單獨進行生物降解;PC組為可見光光催化(無生物膜培養(yǎng));ICPB組為可見光光催化與生物降解耦合。數(shù)字表示抑制區(qū)的半徑減去濾紙的半徑。
r1K新型光催化網(wǎng)_水庫治理_河道治理_水生態(tài)修復(fù)_水環(huán)境治理與修復(fù)_江蘇雙良環(huán)境科技有限公司
5、中文標題:二氧化鈦浸漬+小球藻包覆微結(jié)構(gòu)陶瓷中空纖維對鉻(Ⅵ)的光還原研究
引自:Igor G.F. Costa, Natália M. Terra, Vicelma L. Cardoso, et al. Photoreduction of chromium(VI) in microstructured ceramic hollow fibers impregnated with titanium dioxide and coated with green algae Chlorella vulgaris[J]. Journal of Hazardous Materials, 2019, 379:120837.r1K新型光催化網(wǎng)_水庫治理_河道治理_水生態(tài)修復(fù)_水環(huán)境治理與修復(fù)_江蘇雙良環(huán)境科技有限公司
 r1K新型光催化網(wǎng)_水庫治理_河道治理_水生態(tài)修復(fù)_水環(huán)境治理與修復(fù)_江蘇雙良環(huán)境科技有限公司
r1K新型光催化網(wǎng)_水庫治理_河道治理_水生態(tài)修復(fù)_水環(huán)境治理與修復(fù)_江蘇雙良環(huán)境科技有限公司
圖1 陶瓷中空纖維生產(chǎn)方案r1K新型光催化網(wǎng)_水庫治理_河道治理_水生態(tài)修復(fù)_水環(huán)境治理與修復(fù)_江蘇雙良環(huán)境科技有限公司
 r1K新型光催化網(wǎng)_水庫治理_河道治理_水生態(tài)修復(fù)_水環(huán)境治理與修復(fù)_江蘇雙良環(huán)境科技有限公司
r1K新型光催化網(wǎng)_水庫治理_河道治理_水生態(tài)修復(fù)_水環(huán)境治理與修復(fù)_江蘇雙良環(huán)境科技有限公司
圖2 浸漬TiO2((a)、氧(b)、鋁(c)的不對稱氧化鋁中空纖維載體的EDS圖像r1K新型光催化網(wǎng)_水庫治理_河道治理_水生態(tài)修復(fù)_水環(huán)境治理與修復(fù)_江蘇雙良環(huán)境科技有限公司
 r1K新型光催化網(wǎng)_水庫治理_河道治理_水生態(tài)修復(fù)_水環(huán)境治理與修復(fù)_江蘇雙良環(huán)境科技有限公司
r1K新型光催化網(wǎng)_水庫治理_河道治理_水生態(tài)修復(fù)_水環(huán)境治理與修復(fù)_江蘇雙良環(huán)境科技有限公司
圖3 雜化體系中鉻(Ⅵ)初始濃度對(a)光催化還原和(b)動力學線性擬合曲線的影響r1K新型光催化網(wǎng)_水庫治理_河道治理_水生態(tài)修復(fù)_水環(huán)境治理與修復(fù)_江蘇雙良環(huán)境科技有限公司
r1K新型光催化網(wǎng)_水庫治理_河道治理_水生態(tài)修復(fù)_水環(huán)境治理與修復(fù)_江蘇雙良環(huán)境科技有限公司
在本篇文章中,作者提出了一種新穎的光催化復(fù)合體系,用于從水溶液中還原六價鉻(Cr(VI))。該雜化體系由固定在非對稱氧化鋁中空纖維微孔中的二氧化鈦(tio2)和外層海綿狀綠藻小球藻組成。作者系統(tǒng)地研究了Cr(VI)在不同體系中的光還原反應(yīng):單一TiO2或藻類體系;藻類與TiO2的協(xié)同作用體系;TiO2與藻類復(fù)合的陶瓷中空纖維復(fù)合體系。形態(tài)和能譜分析表明,TiO2和藻類在氧化鋁中空纖維中得到了適當?shù)闹巍.敵跏糃r(VI)濃度為10 mg/L、TiO2和藻類的劑量為1g/L,混合系統(tǒng)在處理16 h后導(dǎo)致Cr(VI)總還原。此外,混合系統(tǒng)的Cr(VI)還原效率在5次重復(fù)使用后僅降低9%,10次重復(fù)使用后僅降低42%。因此,浸漬二氧化鈦并以綠藻C.vulgaris修飾的微結(jié)構(gòu)陶瓷中空纖維對Cr(VI)的還原是有效的。r1K新型光催化網(wǎng)_水庫治理_河道治理_水生態(tài)修復(fù)_水環(huán)境治理與修復(fù)_江蘇雙良環(huán)境科技有限公司
r1K新型光催化網(wǎng)_水庫治理_河道治理_水生態(tài)修復(fù)_水環(huán)境治理與修復(fù)_江蘇雙良環(huán)境科技有限公司
r1K新型光催化網(wǎng)_水庫治理_河道治理_水生態(tài)修復(fù)_水環(huán)境治理與修復(fù)_江蘇雙良環(huán)境科技有限公司
6、中文標題:光催化-電浮選技術(shù)處理富營養(yǎng)化原水的前景r1K新型光催化網(wǎng)_水庫治理_河道治理_水生態(tài)修復(fù)_水環(huán)境治理與修復(fù)_江蘇雙良環(huán)境科技有限公司
引自:Peng H , Jiang S , Xu J , et al. A promising cooperation of photocatalysis and electro-floatation for treatment of eutrophicated raw water[J]. Journal of Cleaner Production, 2020, 275:122564.r1K新型光催化網(wǎng)_水庫治理_河道治理_水生態(tài)修復(fù)_水環(huán)境治理與修復(fù)_江蘇雙良環(huán)境科技有限公司
 r1K新型光催化網(wǎng)_水庫治理_河道治理_水生態(tài)修復(fù)_水環(huán)境治理與修復(fù)_江蘇雙良環(huán)境科技有限公司
r1K新型光催化網(wǎng)_水庫治理_河道治理_水生態(tài)修復(fù)_水環(huán)境治理與修復(fù)_江蘇雙良環(huán)境科技有限公司
圖一 實驗裝置原理圖r1K新型光催化網(wǎng)_水庫治理_河道治理_水生態(tài)修復(fù)_水環(huán)境治理與修復(fù)_江蘇雙良環(huán)境科技有限公司
 r1K新型光催化網(wǎng)_水庫治理_河道治理_水生態(tài)修復(fù)_水環(huán)境治理與修復(fù)_江蘇雙良環(huán)境科技有限公司
r1K新型光催化網(wǎng)_水庫治理_河道治理_水生態(tài)修復(fù)_水環(huán)境治理與修復(fù)_江蘇雙良環(huán)境科技有限公司
圖二 組合工藝原理圖r1K新型光催化網(wǎng)_水庫治理_河道治理_水生態(tài)修復(fù)_水環(huán)境治理與修復(fù)_江蘇雙良環(huán)境科技有限公司
r1K新型光催化網(wǎng)_水庫治理_河道治理_水生態(tài)修復(fù)_水環(huán)境治理與修復(fù)_江蘇雙良環(huán)境科技有限公司
本研究采用光催化與電浮選耦合的方法去除富營養(yǎng)化原水中的藻類和有機物。構(gòu)建了單光催化、單電浮選、光催化和電浮選(組合工藝)等一系列工藝,探討其對污染物的去除效果,探索光催化和電浮選的相互作用機理。據(jù)結(jié)果表明,單個光催化過程對可溶性化學需氧量(SCODMn)、總化學需氧量(TCODMn)和葉綠素a (Chl-a)的去除率分別為55%、14%和30%,組合工藝對上述指標的去除率分別提高到91%、70%和86%。此外,電浮選的存在可以提高光催化劑的光催化活性,這可歸因于電浮選可以提供充足的氧氣,有利于Bi4O5I2(【Hmim】I)/Bi4O5I2(KI)光催化劑產(chǎn)生更具有活性的超氧陰離子,以及產(chǎn)生大量的浮動微氣泡,以增強污染物和光催化劑的傳質(zhì)。本研究將為富營養(yǎng)化原水同時處理藻類和有機質(zhì)提供新思路,為水體的原位富營養(yǎng)化恢復(fù)提供保障。r1K新型光催化網(wǎng)_水庫治理_河道治理_水生態(tài)修復(fù)_水環(huán)境治理與修復(fù)_江蘇雙良環(huán)境科技有限公司
r1K新型光催化網(wǎng)_水庫治理_河道治理_水生態(tài)修復(fù)_水環(huán)境治理與修復(fù)_江蘇雙良環(huán)境科技有限公司
r1K新型光催化網(wǎng)_水庫治理_河道治理_水生態(tài)修復(fù)_水環(huán)境治理與修復(fù)_江蘇雙良環(huán)境科技有限公司